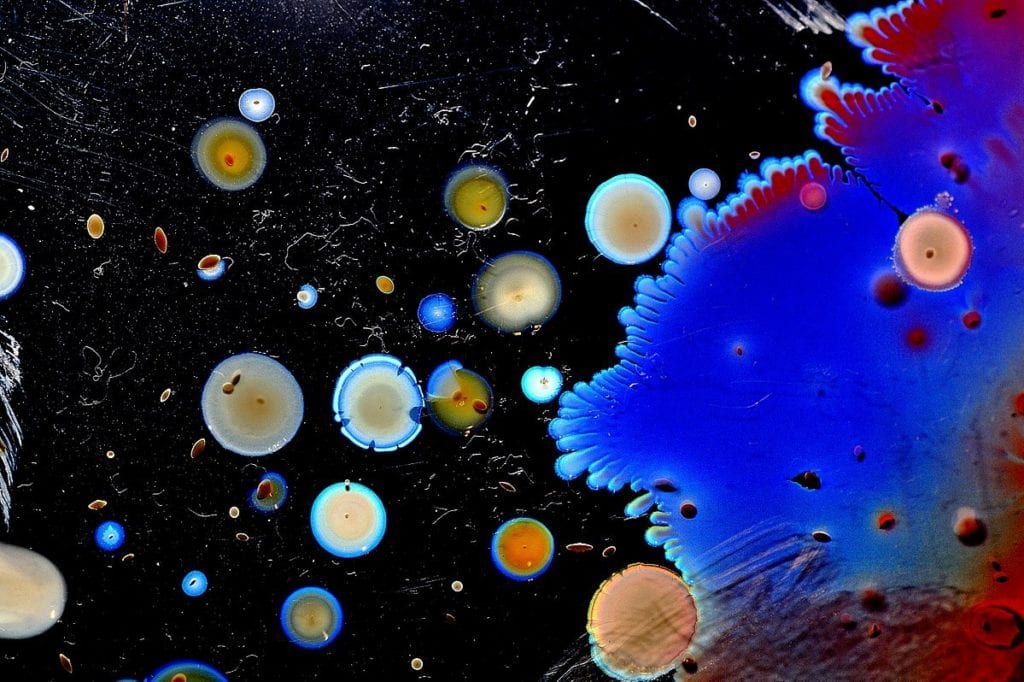

Stefania Rizzelli e il lato artistico di muffe e batteri alimentari
Intervista a Stefania, vincitrice del concorso internazionale di Wikimedia nella categoria “set di immagini” del più grande concorso fotografico scientifico
di Donato Troiano
Ultima Modifica: 25/11/2018
Una modenese di Formigine, 40 anni, perito chimico, pragmatica nell’associare cibo e arte, calma ma tosta, si chiama Stefania Rizzelli e il Quotidiano Nazionale, (QN, Resto del Carlino, La Nazione e il Giorno) le ha dedicato una pagina intera domenica 18 novembre. E a QN Stefania ha dichiarato: “più che chimica o fotografa mi sento artista: tutti noi siamo circondati da arte senza accorgercene”. Una frase “tosta” appunto!

Una pagina intera, con un richiamo nella prima, perché Stefania, come già aveva scritto InformaCibo nelle scorse settimane, è risultata la prima vincitrice internazionale nella categoria “set di immagini” del più grande concorso fotografico scientifico, Wiki Science Competition, il concorso nato sulle piattaforme wikimedia per fornire i migliori e più completi file multimediali scientifici riutilizzabili e accessibili a tutti.

Rizzelli si occupa, come ricercatrice, di muffe di alimenti (carne, cereali, formaggi) che trasforma in suggestive fotografie

Stefania Rizzelli lavora da anni nell’industria alimentare e si occupa di ricerche microbiologiche trattando i batteri e le muffe di alimenti come la carne, cereali, formaggi e altri prodotti alimentari. Grazie a questa esperienza sul campo ha sviluppato una particolarissima tecnica con la quale riesce a ottenere vere e proprie opere d’arte. Di conseguenza queste immagini sono adatte sia per l’istruzione e la scienza dei cittadini, sia come arredamento design. Ma passiamo alle nostre domande.
Chi è Stefania Rizzelli?
Sono un’ artista bio e mi occupo di analisi chimiche e microbiologiche sul cibo in un laboratorio con sede nella mia città natale, Modena, nella regione Emilia-Romagna, considerata da molti come il cuore dei distretti alimentari del Nord Italia.
Ha dimostrato con la fotografia l’esistenza di un’arte naturale e silenziosa creata da batteri presenti negli alimenti, come ha fatto?
La mia – peculiare – arte consiste nel catturare l’affascinante mondo dei microbi e imprimerli su stampe fotografiche destinate alla divulgazione scientifica – e artistica -. Trovo l’arte della natura semplicemente affascinante per la sua spontaneità e la capacità di comunicare in modo sorprendente.
Come nasce il suo progetto scientifico?
Quando ho iniziato il mio vero lavoro, il mio entusiasmo è stato così palpabile che ho quasi subito pensato nello sviluppo di un progetto scientifico associato all’arte che “poteva essere mangiato”. Con la mia esperienza microbiologica, ho iniziato a sperimentare vari alimenti come latticini, cereali, carne, ecc., Fotografando tutto ciò che i batteri stessi creavano.
E poi…..
Dopo circa due anni di ricerca, con un’attenta selezione di quasi 500 scatti di varie specie batteriche, ho avviato il progetto “L’arte invisibile dei batteri”, con l’obiettivo di parlare dell’importanza del mondo microbico. Questo progetto cerca di superare la descrizione pregiudiziale dei microrganismi come nemici, proponendo un approccio positivo e proattivo che si sviluppa sia sul lato scientifico che sul lato artistico, sottolineando l’importanza cruciale che i batteri assumono nella vita umana, animale e vegetale.
Ma come trasforma “in bellezza artistica” i batteri e le muffe degli alimenti?
Il cibo è un argomento universale e un buon punto di partenza per attirare l’attenzione di uno spettatore. Quindi è arte. Le immagini evidenziano la straordinaria bellezza del mondo microbico essenziale per la nostra sopravvivenza. Senza di esso, non ci sarebbe vita, né vegetale né animale. Siamo circondati da batteri e muffe che in silenzio trasformano il nostro cibo e la materia in opere d’arte.
Chi ha partecipato e giudicato il suo lavoro?
La valutazione di oltre 10 mila file ha richiesto l’apporto di molti volontari, con formazione scientifica per apprezzare la qualità e l’originalità delle foto. Mentre ad operare la scelta è stata una giuria di esperti, tra cui Alessandro Marchetti, capo del comitato accademico, Masha Stroobant, incaricata della comunicazione dell’evento e Marcos Valdes.
Ora che è riuscita ad essere la prima vincitrice di questo concorso internazionale cosa ha intenzione di fare?
Continuerò a diffondere il mio progetto perché mi sono resa conto che ha incuriosito molte persone. Vorrei continuare a partecipare a mostre ed eventi anche fuori dai confini nazionali. Sento intorno al mio progetto molto interesse.
Dove si è svolta la premiazione del concorso promosso da Wikimedia in tutto il mondo?
La cerimonia si è svolta presso la Scuola Superiore della Normale di Pisa. Un luogo scientifico per unire strettamente due eccellenze del nostro Paese, che amo molto, l’arte e il cibo.
In bocca al lupo Stefania.
Condividi L'Articolo
L'Autore